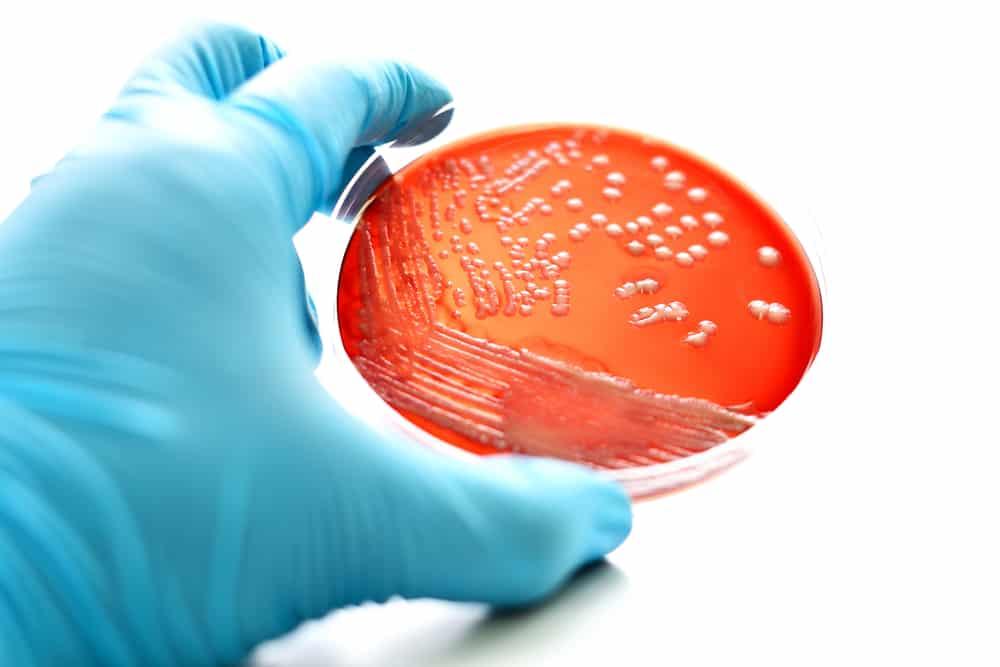
septicemia

ဆွေမျိုးအချင်းချင်း သွေးမသွင်း သင့်တဲ့ အကြောင်းရင်း
ရုပ်ရှင်ထဲမှာဆိုရင်တော့ သားက ဒဏ်ရာရသွားရင် အမေကဖြစ်ဖြစ် 'ကျွန်မကိုယ်ထဲက သွေးကို ယူပါ။ သူ့ကို သွင်းပေးပါ' ဆိုပြီး ပြော၊ သွေးသွင်းပေး သက်သာလာဆိုတဲ့ Happy endingလေး ဖြစ်သွားတတ်ပါတယ်။ လက်တွေ့မှာလည်း ဒီလို လုပ်လို့ရတယ်ဆိုပြီး အမျိုးတစ်ယောက်ယောက် သွေးလိုလို့ သွားလည်း ပေးရော ဆရာဝန်က အမျိုးအချင်းချင်း သွေးသွင်းလို့ မရဘူးပြောရော။ ဘာလို့လဲ။ ကိုယ်အင်္ဂါတွေ လှူရင်တောင် ဆွေမျိုးနီးစပ်တွေထဲက လှူရတာ။ ဆွေမျိုးအချင်းချင်း သွေးမသွင်း သင့်တာက ဘာကြောင့်လဲ။ ဆွေမျိုးအချင်းချင်း သွေးမသွင်း သင့်တာ ဒါကြောင့်ပါ။ ဆွေမျိုးအချင်းချင်း သွေးသွင်းတဲ့အခါ အခန့်မသင့်ရင် Transfusion Associated Graft-Versus-Host Disease (TA-GVHD) ဆိုတာ ဖြစ်တတ်ပါတယ်။ ဒါက ရှားပေမယ့် ဖြစ်လာရင် သေနှုန်းက ၉၀ ရာခိုင်နှုန်းလောက် ရှိပါတယ်။ ဟိုးအရင်တုန်းက […]